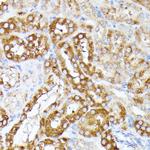
CLNS1A Antibody in Immunohistochemistry (Paraffin) (IHC (P))

Search
Invitrogen
CLNS1A Polyclonal Antibody
{{$productOrderCtrl.translations['antibody.pdp.commerceCard.promotion.promotions']}}
{{$productOrderCtrl.translations['antibody.pdp.commerceCard.promotion.viewpromo']}}
{{$productOrderCtrl.translations['antibody.pdp.commerceCard.promotion.promocode']}}: {{promo.promoCode}} {{promo.promoTitle}} {{promo.promoDescription}}. {{$productOrderCtrl.translations['antibody.pdp.commerceCard.promotion.learnmore']}}
图: 1 / 4
CLNS1A Antibody (PA5-109555) in IHC (P)

Please note: We are reviewing Western blot images included in the antibody testing data in our catalog, including those provided by third parties. Unless expressly labeled or annotated as “raw-unedited”, Western blot images included in the antibody testing data in our catalog may have been edited, optimized or otherwise adjusted for presentation.
产品信息
PA5-109555
种属反应
宿主/亚型
分类
类型
抗原
偶联物
形式
浓度
规格
纯化类型
保存液
内含物
保存条件
运输条件
RRID
产品详细信息
Immunogen sequence: MSFLKSFPPP GPAEGLLRQQ PDTEAVLNGK GLGTGTLYIA ESRLSWLDGS GLGFSLEYPT ISLHALSRDR SDCLGEHLYV MVNAKFEEES KEPVADEEEE DSDDDVEPIT EFRFVPSDKS ALEAMFTAMC ECQALHPDPE DEDSDDYDGE EYDVEAHEQG QGDIPTFYTY EEGLSHLTAE GQATLERLEG MLSQSVSSQY NMAGVRTEDS IRDYEDGMEV DTTPTVAGQF EDADVDH
靶标信息
Putative Polycomb group (PcG) protein. PcG proteins act by forming multiprotein complexes, which are required to maintain the transcriptionally repressive state of homeotic genes throughout development. PcG proteins are not required to initiate repression, but to maintain it during later stages of development. They probably act via methylation of histones, rendering chromatin heritably changed in its expressibility. Involved in transcriptional regulation mediated by ligand-bound nuclear hormone receptors, such as peroxisome proliferator-activated receptor gamma (PPARG). Acts as coactivator for PPARG and enhances its adipocyte differentiation-inducing activity; the function seems to involve differential recruitment of acetylated and methylated histone H3.
⚠WARNING: This product can expose you to chemicals including mercury, which is known to the State of California to cause birth defects or other reproductive harm. For more information go to www.P65Warnings.ca.gov.
仅用于科研。不用于诊断过程。未经明确授权不得转售。
篇参考文献 (0)
生物信息学
蛋白别名: ARPC1A; chloride channel current inducer; chloride channel regulator; Chloride channel, nucleotide sensitive 1A; Chloride conductance regulatory protein ICln; Chloride ion current inducer protein; ClCI; Clns 1a; I(Cln); Methylosome subunit pICln; Reticulocyte pICln; SOP2-like protein; SOP2L
基因别名: 2610036D06Rik; 2610100O04Rik; CLCI; Clcni; CLNS1A; ICLN; pICln; Rcl1
UniProt ID: (Rat) Q04753
Entrez Gene ID: (Mouse) 12729, (Rat) 65160




